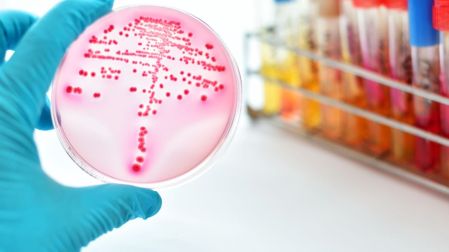
thumb

Aumentan casos de bacterias de pesadilla: qué son y cómo se transmiten
Casos de bacterias “pesadilla” resistentes a los antibióticos crecieron más del 460 % en Estados Unidos en cuatro años.

En los últimos años, Estados Unidos enfrenta un aumento considerable en infecciones causadas por bacterias resistentes a los antibióticos, conocidas popularmente como “bacterias de pesadilla”.
Expertos de salud estadounidenses advierten que estas bacterias representan un desafío creciente para la salud pública debido a su capacidad para evadir tratamientos convencionales y propagarse rápidamente en entornos hospitalarios.
¿Qué representan las bacterias “pesadilla” o CRE?
Los Centros para el Control y la Prevención de Enfermedades (CDC) utilizan el término “bacterias de pesadilla” para referirse a las enterobacterias resistentes a los antibióticos carbapenémicos (CRE) que producen ciertas enzimas —como la NDM— que les permiten evadir incluso los fármacos más poderosos.
Estas bacterias son un problema grave porque pueden generar infecciones severas difíciles de tratar. Según el CDC, la aparición de estas cepas ha escalado hasta convertirse en una amenaza cada vez más seria para la salud pública.
Te puede interesar: Muertes por resistencia a antibióticos aumentarán en los próximos 30 años
¿Cómo surge esta resistencia y qué papel desempeña el gen NDM?
La resistencia a los antimicrobianos ocurre cuando las bacterias mutan y adoptan mecanismos que les permiten sobrevivir frente a fármacos diseñados para matarlas.
En el caso de las CRE, algunas bacterias adquieren genes que codifican enzimas llamadas carbapenemasas; estas enzimas inactivan los antibióticos carbapenémicos al degradarlos.
Entre esas enzimas, destaca la NDM (New Delhi metallo‑β-lactamasa), cuya presencia confiere resistencia a casi todos los carbapenémicos disponibles. Cuando una bacteria porta ese gen, las opciones de tratamiento se reducen considerablemente.
El uso inadecuado de antibióticos ha acelerado este proceso. Algunas maneras en que esto sucede incluyen:
- No completar el tratamiento indicado, lo que permite que queden bacterias sobrevivientes que desarrollen resistencia.
- Recetar antibióticos cuando no son necesarios o usar dosis incorrectas, lo que favorece que las bacterias “aprendan” a resistirlos.
¿Dónde se propagan y por qué son más frecuentes en hospitales?
Aunque el número absoluto de personas con infecciones por bacterias resistentes sigue siendo bajo en muchos países, su crecimiento en los últimos años es alarmante, señala un reciente informe del CDC.
En Estados Unidos, por ejemplo, la CDC también reporta que los casos de CRE con el gen NDM se incrementaron más del 460 % entre 2019 y 2023.
En 2023, se documentaron 4,341 casos de infecciones por CRE en 29 estados que reportan estos datos; de estos, 1,831 estaban asociados a la variante NDM.
Sin embargo, estos números podrían subestimar la magnitud del problema. No todos los estados tienen la capacidad para realizar pruebas genéticas avanzadas ni reportan consistentemente estos casos.

Te puede interesar: Paracetamol e ibuprofeno juntos: el riesgo oculto que alimenta la resistencia a los antibióticos
¿Por qué los hospitales son focos principales de transmisión?
- Los pacientes hospitalizados suelen tener vulnerabilidades: uso de catéteres, ventiladores, heridas abiertas o sistemas inmunitarios debilitados.
- La transmisión puede ocurrir entre pacientes o mediante superficies, equipos médicos o manos contaminadas del personal sanitario.
- Una vez que estas bacterias se establecen dentro de un hospital, pueden desplazarse entre salas y dispositivos, especialmente cuando no hay protocolos rígidos de control de infecciones.

Te puede interesar: “Los antibióticos mejoran la evolución de la gripe”
¿Cómo identificar una infección resistente a los carbapenémicos?
Detectar una infección por CRE no es sencillo, pues los síntomas suelen ser similares a los de infecciones bacterianas comunes. No obstante, ciertos signos pueden servir como advertencia:
- Infecciones urinarias: ardor al orinar, necesidad frecuente de ir al baño, orina turbia.
- Infecciones del torrente sanguíneo: fiebre muy alta, latidos acelerados o presión arterial sumamente baja.
- Neumonía (pulmones): tos persistente, dificultad para respirar o dolor en el pecho.
Estas manifestaciones no son exclusivas de CRE, por lo que el médico debe sospechar resistencia cuando el paciente no responde a tratamientos habituales o pertenece a un ambiente hospitalario de riesgo. Identificar temprano la resistencia es crucial para elegir el antibiótico adecuado y evitar la propagación.
Las bacterias de pesadilla —o CRE con genes como el NDM— representan una amenaza real para la salud moderna. Su capacidad de resistir incluso los antibióticos más potentes convierte cualquier infección que provocan en un reto médico.
El incremento reciente documentado en Estados Unidos —un aumento de más del 460 % en infecciones NDM entre 2019 y 2023— ilustra que no estamos ante una advertencia lejana, sino ante una situación que exige acción inmediata.
EL EDITOR RECOMIENDA
Ozempic será genérico; expira patente y bajarán precios
Salud 3 min de lectura
Alertan por suplemento popular que podría alimentar el cáncer
Salud 4 min de lectura